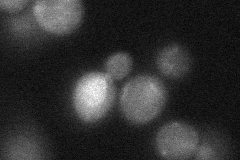

View description
Reverse transcriptase subunit of the telomerase holoenzyme, essential for telomerase core catalytic activity, involved in other aspects of telomerase assembly and function; mutations in human homolog are associated with aplastic anemia
Localization:
Intensity:
Fold change:
Significance:
-
C’ GFP library in SD

below threshold17.21 -
N' NOP1pr-GFP in SD

nucleolus27.524 -
N' TEF2pr-mCherry in SD

nucleus,nucleolus9.73459 -
N' NATIVEpr-GFP in SD

below threshold20.2604 -
N' TEF2pr-VC and Cyto-VN in SD
below threshold23.8591 -
C’ GFP library in SD+DTT

cytosol15.390.89No -
C’ GFP library in SD+H2O2

cytosol16.70.97No -
C’ GFP library in Starvation Media

cytosol15.130.87No -
C’ GFP library on the background of Pup2-DaMP

below threshold -
C’ GFP library on the background of CCT mutant

below threshold17.9611.04308No
